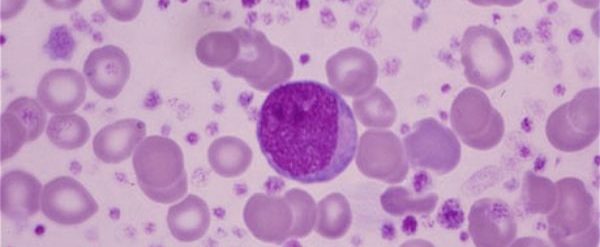
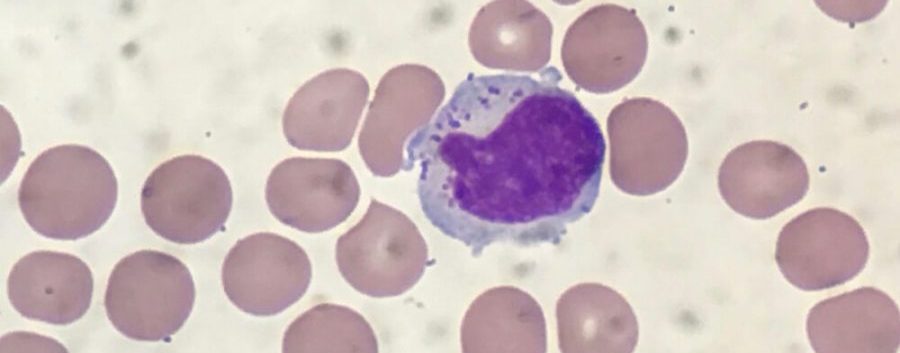

|
# # # # In general, your immune system does a truly amazing job of keeping you healthy and the dangerous pathogenic world around us at bay. Trillions of cells constantly monitoring for viruses and other illness-causing agents, and ruthlessly disposing of any that they actually find. But sometimes your immune system can get a little carried away with this task and researchers have developed medications that turn down the volume of immune system activity. Recently, researchers have reported new data that points towards a particular class of immune cells (lymphocytes) in Parkinson’s, and they have also identified a pathway that could be targeted therapeutically. In today’s post, we will discuss what lymphocytes are and consider new data highlighting an immunomodulation treatment avenue that could be explored in Parkinson’s. # # # # |
 Your hematopoietic system. Source: Wikipedia
Your hematopoietic system. Source: Wikipedia
The process of hematopoiesis (or blood formation) is absolutely fascinating.
Seriously.
You start off with a single, multi-potential hematopoietic stem cell. This is called a hemocytoblast (it’s the big cell in middle of the image below):
A hemocytoblast. Source: Pinterest
A hemocytoblast. Source: Pinterest
Given enough time, this single cell will give rise to an entire blood system, made up of many of different types of cells (as displayed in the schematic above) with very specific functions that are required for us to live normal lives.
It is a remarkable achievement of biology.
Understand that at any moment in time your blood system will contain 20-30 trillion cells (in the average human body). And as the image near the top of the post suggests, there are quite a few branches of potential cell types that these blood stem cells can generate.
Very interesting, but what does this have to do with Parkinson’s?
A lot.
And what we need to do today to make our way down one of those branches to a particular type of blood cell, which we are going to be focusing on today.
Blood accounts for approximately 7% of your body weight, and the average adult has a blood volume of roughly 5 litres (11 US pints).
There are three chief components of blood:
- Red blood cells
- White blood cells
- Plasma (92% water and 8% other stuff – think blood clotting proteins, waste, nutrients, etc)
By volume, the red blood cells constitute about 45% of whole blood, the plasma about 54.3%, and white cells about 0.7%.
 Source: KhanAcademy
Source: KhanAcademy
When it comes to the cellular parts of blood, one cubic millimeter of blood contains:
- Approximately 5 million erythrocytes, which are ‘red blood cells’ that distribute oxygen around the body. These are small, bi-concave shaped cells that lack any nucleus, but this extra space allows for more hemoglobin – the critical protein involved in transportation of oxygen.
 Source: KhanAcademy
Source: KhanAcademy
- 200,000–500,000 thrombocytes, (also known as platelets) which take part in blood clotting. Thrombocytes are are not actually cells, but rather cell fragments. They are produced by large cells called megakaryocytes which each release 2-3000 platelets in their life time. Platelets are small (2-4 micrometers), lens-shaped structures that float around in the blood system waiting to help plug a rupture.
 Source: KhanAcademy
Source: KhanAcademy
- 5,000–10,000 leukocytes, which are the white blood cells that form the body’s immune system – chewing up and removing old or rogue cells or waste, as well as attacking any foreign or infectious agents.
For the rest of this post, we are going to focus on a particular type of leukocyte.
What are leukocytes?
Leucocytes (or ‘white blood cells’) are the part of the blood system involved in protecting the body against both infectious disease and foreign invaders
They can be divided into two different groups based on what they look like under a microscope:
- granulocytes – which have tiny granules inside them
- agranulocytes – which do not have tiny granules inside them (simple enough)
This division can broken down further into five major subtypes:
 Source: KhanAcademy
Source: KhanAcademy
And while it would bring me endless pleasure to discuss the roles of each of these sub-types, I will spare you that torturous fate and dedicate the rest of this post to the cell on the far right (of the image, not political persuasion).
That cell is a lymphocyte.
What are lymphocytes? And when does any of this actually get back to Parkinson’s?
When your body is attacked by a pathogen (a disease causing agent) like the common cold virus, it will elicit what is called an immune reaction. The presence of the virus inside the body will be detected by cells in the immune system and given that the virus will be clearly determined to be ‘not self’ (or not part of your body), an immune response will be initiated.
The cells that carry out the immune response are the lymphocytes.

That big cell in the middle is a lymphocyte. Source: ASH
There are basically three types of lymphocytes:
- B cells
- Natural killer cells (cool name right?)
- T cells
B cells, Natural killer cells and T cells are highly specialised blood cells that defend our body when things go wrong (which they inevitably do, it’s just the way life is!).
B cells are bone marrow-derived cells which produce Y-shaped proteins called antibodies that are used to label the invading pathogens (such as viruses), and alert other immune cells that these unwanted pathogens need to be disposed of. By sticking to pathgens, antbodies can also block them from doing their function.

Antibodies. Source: Astrazeneca
Utterly useless pub quiz fact: The ‘B’ doesn’t come from ‘bone’ or ‘blood’, but rather it comes from the name of the place these cells were discovered: the Bursa of Fabricus. The Bursa is an organ only found in birds.
 Source: Askabiologist
Source: Askabiologist
B cells do not kill pathogens, they just spend their short life producing antibodies which trap and neutralise them.
The killing of pathogens is left to the natural killer cells and T cells.
Natural killer cells were first noticed because of their ability to kill cancer tumour cells, but what made them particularly interesting was that their approach to killing: it occurred without any priming or prior activation. Natural killer cells are truly the sociopaths of the immune system – if they don’t like the looks of something, they just kill it (shoot first, ask questions later).
In the image below, you can see a large purple/blue cell (this is a natural killer cell) making contact with lots of other cells.
A NK cell. Source: Dana-Faber
A NK cell. Source: Dana-Faber
Thymus-derived T cells kill cells, on the other hand, are ‘primed’ (by antigen presenting cells) to target very specific pathogens. They are the precision, tactical weapons of the immune system.
T cells can be identified by the presence of a T-receptor on their surface. This T-receptor identifies antigens (a molecule capable of inducing an immune response) and binds to them, which activates the T cell. Each T cell targets a specific antigen.
In a nutshell: Natural killer cells kill any thing that doesn’t look right to them, while T cells kill a specific, unique target.
Just remember that lymphocytes are important for the immune response when pathogens are present.
|
# RECAP #1: Blood cells have very specific functions. Red blood cells carry oxygen to all of the tissues of the body, while white blood cells are involved in the immune response to pathogens and damage. Leucocytes are the white blood cell, and of these cells, lymphocytes are responsible for targeting pathogens (or disease causing agents) and carrying out the immune response.. # |
Ok, so we have B cells, Natural killer cells, and T cells. But why are lymphocytes of interest to Parkinson’s?
Because the infiltration of lymphocytes into the brain has been suggested to play a key role in the neurodegeneration that is observed in Parkinson’s – particularly during the early stages of the condition.
In 2009, this report was published:
 Title: Infiltration of CD4+ lymphocytes into the brain contributes to neurodegeneration in a mouse model of Parkinson disease.
Title: Infiltration of CD4+ lymphocytes into the brain contributes to neurodegeneration in a mouse model of Parkinson disease.
Authors: Brochard V, Combadière B, Prigent A, Laouar Y, Perrin A, Beray-Berthat V, Bonduelle O, Alvarez-Fischer D, Callebert J, Launay JM, Duyckaerts C, Flavell RA, Hirsch EC, Hunot S.
Journal: J Clin Invest. 2009 Jan;119(1):182-92.
PMID: 19104149 (This report is OPEN ACCESS if you would like to read it)
In this study, the researchers wanted to determine if Parkinson’s was associated with leukocyte infiltration of the brain, and if this process contributes to degeneration. So the investigators analysed postmortem sections of brain and found that levels of both CD8 and CD4 lymphocytes are elevated in the substantia nigra of people with Parkinson’s.
 Source: PMC
Source: PMC
As as have previously discussed, the substantia nigra is the region of the brain where the dopamine neurons reside and is extremely vulnerable in Parkinson’s. And other groups have reported similar results (Click here for another example)
A more recent recently published study dug even deeper into this lymphocyte infiltration of the brain situation in Parkinson’s:
 Title: CD8 T cell nigral infiltration precedes synucleinopathy in early stages of Parkinson’s disease.
Title: CD8 T cell nigral infiltration precedes synucleinopathy in early stages of Parkinson’s disease.
Authors: Galiano-Landeira J, Torra A, Vila M, Bové J.
Journal: Brain. 2020 Dec 1;143(12):3717-3733.
PMID: 33118032 (This report is OPEN ACCESS if you would like to read it)
In this study, the researchers looked at a large set of brains from people with Parkinson’s and Lewy body disease, and categorised them into four different stages of the diseases (stage 1 being first hints of Parkinson’s in the brain (such as alpha synuclein protein build up in just the olfactory region or brainstem region of the brain) to stage 4 which involved alpha synuclein protein aggregation being present throughout the brain). The progression (from 1 to 4) of the cases through these stages was associated with a general worsening pathology and clinical symptoms.
The researchers found that the brains that fell into stage 1 of the staging system had higher levels of lymphocyte than any of the other stages. And it is important to understand that in stage 1, there is no Lewy bodies present in the substantia nigra and no loss of dopamine neurons. This finding suggested to the researchers that lymphocyte infiltration precedes both alpha synuclein aggregation and the loss of dopamine neurons (starting in stage 2 – see graphs below).
 Interesting. So lymphocyte infiltration of the brain could be an early step in the development of Parkinson’s. Are there any biomarkers associated with this early stage.
Interesting. So lymphocyte infiltration of the brain could be an early step in the development of Parkinson’s. Are there any biomarkers associated with this early stage.
No there are not.
But a study published in 2021 points towards an interesting means of exploring the idea of lymphocyte infiltration.
This is the study in question:
 Title: Sphingosine-1-Phosphate, Motor Severity, and Progression in Parkinson’s Disease (MARK-PD).
Title: Sphingosine-1-Phosphate, Motor Severity, and Progression in Parkinson’s Disease (MARK-PD).
Authors: Schwedhelm E, Englisch C, Niemann L, Lezius S, von Lucadou M, Marmann K, Böger R, Peine S, Daum G, Gerloff C, Choe CU.
Journal: Mov Disord. 2021 Sep;36(9):2178-2182.
PMID: 34008894 (This report is OPEN ACCESS if you would like to read it)
In this study, the researchers collected blood samples from 196 people with Parkinson’s (64% male, average age 68 years, and an average disease duration of 9 years (ranging from 5–13 years). They measured the level of S1P in these samples and compared them to blood collected from 196 age- and sex-matched unaffected control individuals.
What is S1P?
Sphingosine-1-phosphate (S1P) is a bioactive molecule that is ubiquitously present in the human body. It plays an important role in the immune system. It functions via small proteins on membrane surfaces called S1P receptors (S1PR). Modulation on S1P is used as a treatment of autoimmune conditions, like multiple sclerosis.
S1P exerts its action through many different enzymatic reactions in our bodies, but the primary function of S1P is regulating the release of lymphocytes into the systemic circulation.
And this is interesting, given the findings of this new study: the investigators found that S1P concentrations were (on average) lower in the PD group when compared to the controls, (see panel A in the image below):
 Source: Wiley
Source: Wiley
More importantly, when the researchers compared serum S1P concentrations in the Parkinson’s group, they found that the levels were inversely associated with the severity of motor features – in other words, the lower the levels of S1P, the higher the rate of motor symptoms progression.
It should be noted that no associations were found between S1P levels and cognitive function.
So if S1P levels were low, the prognosis was more rapid progression of motor symptoms, but no difference in cognitive decline?
Exactly.
And what is particularly interesting about result is that if S1P concentrations at baseline were below the median levels, this was associated with motor decline during follow-up assessments (typically 18 months later).
If this result is independently replicated in other (larger) Parkinson’s cohorts, then this could make S1P levels a biomarker for patient stratification and treatment.
It could also allow for targeted testing of drugs that modulate S1P in people with Parkinson’s.
|
# # RECAP #2: Lymphocytes have been reported to enter the brain during the very early stages of Parkinson’s. A protein (S1P) associated with release of lymphocytes has been found to be low in people with Parkinson’s, and very low levels are correlated with worse motor symptom progression. # # |
Are there any drugs that modulate S1P?
Yes, there are.
In 1992 researchers at Yoshitomi Pharmaceuticals identified a natural product, called myriocin, that possessed strong immunosuppressive properties. Myriocin was derived from certain fungi (Ascomycota), and after some chemical modification, a drug called FTY720 was produced.
 Ascomycota. Source: Wikipedia
Ascomycota. Source: Wikipedia
FTY720 was found to be a S1P receptor modulator – binding to the receptor and causing it to be internalized, thus removing it from the cell surface. It was initially developed and tested as a immunosuppressant medication for preventing organ transplantation rejection, but positive preclinical research did not translate with the same success to the clinic.
Despite this early setback, FTY720 was tested in models of multiple sclerosis and found to have extremely positive effects by multiple independent investigators. This lead to a series of positive clinical trials, and FTY720 was renamed fingolimod.
Fingolimod. Source:Wikipedia
For those interested in the development and history of FTY720, click here for an excellent review.
Long story short, the clinical trials were successful and in September 2010, fingolimod became the first oral disease-modifying drug approved by the U.S. Food and Drug Administration (FDA) to reduce relapses and delay disability progression in patients with relapsing forms of multiple sclerosis.
Remind me, what is multiple sclerosis?
Multiple sclerosis (or MS) is a chronic neuroimmunologic condition in which the immune system starts to attack the insulating protective covering (or myelin) on the branches (or axons) of neurons.
 Source: Medlineplus
Source: Medlineplus
As that myelin is lost, signaling between neurons becomes weaker and disrupted, and a range of symptoms start to show themselves. Symptoms can include double vision, blindness in one eye, muscle weakness and trouble with sensation or coordination.
Like Parkinson’s, there is no cure for MS.
This video explains MS:
Got it. Has fingolimod ever been investigated in the context of Parkinson’s?
Yes.
There have been a number of preclinical studies. For example:
 Title: Neuroprotective effects of fingolimod in mouse models of Parkinson’s disease.
Title: Neuroprotective effects of fingolimod in mouse models of Parkinson’s disease.
Authors: Zhao P, Yang X, Yang L, Li M, Wood K, Liu Q, Zhu X.
Journal: FASEB J. 2017 Jan;31(1):172-179.
PMID: 27671228 (This report is OPEN ACCESS if you would like to read it)
In this study, the researchers tested fingolimod on two neurotoxin models of Parkinson’s (6-OHDA and rotenone). They found that fingolimod treatment significantly reduced the motor function issues, diminished the loss of dopamine neurons in the substantia nigra, and stopped the decrease of dopamine levels in the brain in both models.
Other independent research groups have reported similar results (Click here and here for some examples). Fingolimod has also been reported to rescue alpha synuclein-based models of Parkinson’s (Click here and here to read more about this). It should be noted that there has been a report that has not observed a neuroprotective effect in preclinical models of Parkinson’s (Click here to read that report), but fingolimod has been reported to be neuroprotective in models of other neurodegenerative conditions (such as Alzheimer’s – click here and here to read examples of studies on this topic)
Has anyone looked at fingolimod and the lymphocyte effect in the brains of these Parkinson’s models?
Yes, in 2021, this report was published:
 Title: CD4 T cells mediate brain inflammation and neurodegeneration in a mouse model of Parkinson disease.
Title: CD4 T cells mediate brain inflammation and neurodegeneration in a mouse model of Parkinson disease.
Authors: Williams GP, Schonhoff AM, Jurkuvenaite A, Gallups NJ, Standaert DG, Harms AS.
Journal: Brain. 2021 Aug 17;144(7):2047-2059.
PMID: 33704423 (This report is OPEN ACCESS if you would like to read it)
In this study, the researchers found that inducing high levels of alpha synuclein protein in the midbrain of mice resulted in the infiltration of lymphocytes (predominantly CD4 T cells) into the brain. The investigators wanted to assess whether reducing CD4 T cells would impact the neurodegeneration observed in this model. They tested this two ways, firstly via genetically engineering mice that did not produce CD4 T cells, and secondly by treating normal mice with fingolimod.
In both cases, the researchers observed a reduction in the number of CD4 T cells entering the brain, and significantly less neurodegeneration.
But before rushing into clinical testing of fingolimod in a Parkinson’s cohort, however, the investigators suggest that:
“Critical next steps for the possible use of T cell therapies in Parkinson’s disease would be the further characterization of the signals those T cells produce and their effect in Parkinson’s disease. From there, multiple targeting paradigms already exist to dampen T cell responses in human disease which include their depletion, inhibiting their trafficking, or neutralizing the pro-inflammatory signals they are producing”
Interesting. So what does it all mean?
Before we sum up, there is one other interesting piece of research that I wanted to highlight.
This report:
 Title: The p75 neurotrophin receptor as a novel intermediate in L-dopa-induced dyskinesia in experimental Parkinson’s disease.
Title: The p75 neurotrophin receptor as a novel intermediate in L-dopa-induced dyskinesia in experimental Parkinson’s disease.
Authors: Liu Z, Yan A, Zhao J, Yang S, Song L, Liu Z.
Journal: Exp Neurol. 2021 Aug;342:113740.
PMID: 33971218
In this study, the researchers wanted to explore the functional role of the p75 neurotrophin receptor (p75NTR) in Parkinson’s associated dyskinesia.
What is dyskinesia?
Dyskinesias are involuntary muscle movements associated with long-term use of levodopa therapy (use of levodopa is not a certainty for developing dyskinesias, but there is an association). A better understanding of the underlying biology of dyskinesias is required in order to alleviate this condition for those affected by it (Click here to read a previous SoPD post on this topic).
In this study, the researchers found that levels of p75NTR protein was significantly elevated in the brains of mice that had been lesioned with a neurotoxin to model Parkinson’s. By artificially elevating these levels of p75NTR protein further, the scientists found that they exaggerated the dyskinesias that developed in these animals, while reducing p75NTR protein levels prevented the development of dyskinesias.
How did they reduce the levels of p75NTR protein?
By treating the animals with fingolimod.
Not only did fingolimod reduce dyskinesias (without lessening the therapeutic efficacy of L-dopa), but it also normalized levels of p75NTR protein.
Thus, there may be a symptomatic benefit as well as neuroprotective effect to explore in future clinical trials of fingolimod in Parkinson’s cohorts.
So what does it all mean?
In September 2010, fingolimod became the first oral disease-modifying therapy to be approved by the U.S. Food and Drug Administration (FDA) for treatment in patients with relapsing forms of multiple sclerosis. It represented a significant development for the multiple sclerosis community. Gilenya (the brand name of fingolimod) became a top selling product for its maker Novartis, with annual revenues of $3.34 billion (at a list price of $95,594 annually – source). In late 2019, the US FDA approved three generic versions of Gilenya, amid a legal battle by Novartis to prevent these competitors from taking any market share (Source).
It is a fight that Novartis is losing (Source).
The fact that generic forms of fingolimod are now available means that this agent could become an interesting candidate for repurposing to other neurodegenerative conditions, such as Parkinson’s. As discussed above, some more research is required before initiating clinical trials, but this anti-inflammatory approach is already supported by some encouraging preclinical data and could be interesting to initially test in the very early stages (the prodromal phase) of Parkinson’s perhaps.
 All of the material on this website is licensed under a
All of the material on this website is licensed under a
Creative Commons Attribution 4.0 International License
You can do whatever you like with it!
The banner for today’s post was sourced from wikipedia


cubic millimeter
LikeLike
Opps! Thanks Peter. Corrected.
LikeLike
Simon
I found Brain on Fire very interesting.
LikeLike
Wow. If the marshaling of lymphocytes to the substantia nigra precedes Lewy body pathology there, then I have to wonder what impact this observation will have on our understanding of Braak’s hypothesis. Might it be that misfolded alpha synuclein does reach the nigrostriatal area as per Braak, but before Lewy bodies appear the S1P receptors are triggered, calling in the lymphocytes? That would not require any serious modification of Braak according to my own imperfect understanding.
Also, I’m not sure how to read the *inverse* association of S1P levels and motor symptom severity. Are S1P levels lower in more severe cases because they have been *used up* in the course of activating S1P receptors? And are they triggering those receptors more urgently in response to the presence of misfolded/aggregated alpha synuclein that has arrived by spreading along axons per Braak?
LikeLike
I mean, if we consider the three charts of T-Cells, Lewy pathology and neurons, we see that Lewy pathology takes off exactly when T-cell infiltration has peaked. So since you can’t have Lewy bodies without first having misfolded alpha-synuclein, doesn’t that suggest that misfolded alpha-synuclein was already present at the point that Lewy pathology starts to take off (and therefore also at some time *prior* to when T-cell infiltration has peaked)?
I read somewhere that an adaptive immune response to misfolded alpha-synuclein may be generated as early in Braak as when a virus or other inciting factor lands in the gut and first causes some alpha-synuclein to misfold. And we can see that there is inflammation of the vagus nerve and other autonomic nervous system conduits that impedes autonomic function, causing various prodromal symptoms, so why would it require the presence of Lewy bodies to trigger the marshaling of T-cells to the nigrostriatal area? That is, why wouldn’t merely misfolded alpha-synuclein be sufficient?
LikeLike
A Seattle researcher, Mischly (spelling?) published a paper several years ago, in which she examined correlations between consumption of various nutrients/additives and the progression rates of Parkinson’s patients in her database composed of her own patients. It turned out that there was little significant correlation for most of the substances evaluated, with one sterling exception – fish oil, which also has a reputation as a beneficial substance for treatment of MS, reputedly through the mechanism of being protective of myelin sheaths. Yet another intriguing connection btween MS and PD.
LikeLike